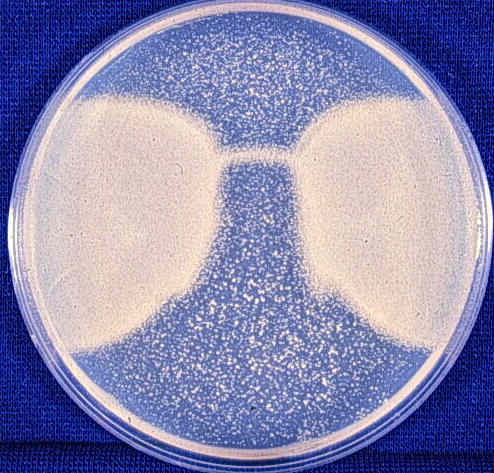

| Figure 1 |
|---|

|
| Strain: G948-1C The cells on one half of the plate were shaded with dark paper. 1/4 were shaded with sunscreen and 1/4 were unprotected. The plate was exposed to sunlight for 4 min. The cells under the paper grew well. The cells under the sunscreen grew little. The unprotected cell barely grew at all. |
| Figure 2 |
|---|
|
Strain G948-1C used as bioassay. The plate was exposed to sunlight while a portion of the cells were shaded with sunglasses. |